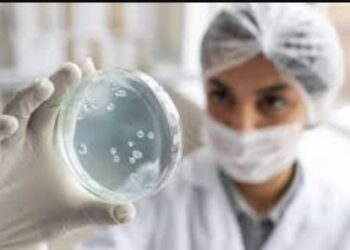
antimicrobial resistance

New Delhi : Can Alzheimer’s be completely reversed? This is not just about preventing it or ensuring it that the disease slow down, but can it be reversed to achieve full neurological recovery? For the longest, we have known that Alzheimer’s is a progressive, degenerative brain disease, which destroys memory, thinking, and eventually the ability to perform simple tasks, but now a team of researchers from Case Western Reserve University, University Hospitals (UH), and Louis Stokes Cleveland VA Medical Center has challenged this belief. They may have found out something that could reverse it, at least so says the animal model.
Instead of targeting plaques or tangles alone, the team looked at something more fundamental: the brain’s energy system.
Their findings, published in Cell Reports Medicine, suggest that restoring the brain’s energy balance may not just slow Alzheimer’s but potentially reverse key features of the disease, at least in animal models.
What Did The Study Find?
The study is led by Kalyani Chaubey from the Pieper Laboratory, and at the center of the study is NAD+, a molecule essential for cellular energy and repair.
NAD+ levels naturally decline with age across the body, including in the brain. When levels drop too low, cells struggle to perform basic functions and eventually fail.
The researchers found that this decline is far more severe in the brains of people with Alzheimer’s. The same sharp drop was also seen in mouse models of the disease, pointing to a shared biological problem.
How the study was conducted
While Alzheimer’s is uniquely human, scientists use specially engineered mice to study it. In this study, two types of mice were used. One model carried human mutations linked to amyloid buildup, while the other carried a mutation affecting the tau protein.
Both amyloid and tau are central to Alzheimer’s pathology. Over time, these mice developed symptoms similar to human Alzheimer’s, including brain inflammation, damage to nerve fibers, breakdown of the blood-brain barrier, reduced formation of new neurons, and severe memory and learning problems.
Restoring energy balance in diseased brains
After confirming that NAD+ levels were dramatically reduced, the researchers tested whether restoring this balance could help. They used a drug called P7C3-A20, developed in the Pieper Laboratory, which supports cells in maintaining healthy NAD+ levels under stress.
Remarkably, the results went beyond prevention. Even when treatment began after significant disease progression, the mice showed reversal of major brain damage. Cognitive function fully recovered in both mouse models, despite their different genetic causes.
Biomarkers and what they signal
The recovery was not just behavioral. Blood levels of phosphorylated tau 217, a biomarker now used clinically in humans to detect Alzheimer’s, returned to normal in treated mice. This provided objective evidence that disease processes had been reversed, not merely masked.
Why this matters for people
The findings suggest a possible paradigm shift. Alzheimer’s damage may not always be permanent. Under certain conditions, the brain appears capable of repairing itself and regaining function.
However, the researchers caution against self-medicating with over-the-counter NAD+ supplements. Some have been shown in animal studies to raise NAD+ to unsafe levels that may increase cancer risk. The drug used in this study works differently, supporting balance rather than excess.